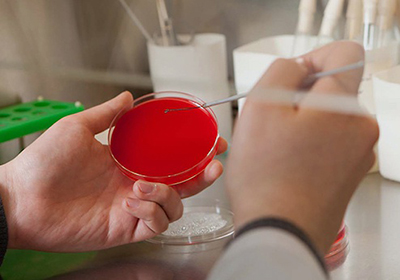

Сдать кровь на вич в вязьме
Дата публикации: 18 апреля 2017 . Категория: Полезная информация.
В ОГБУЗ "Вяземская ЦРБ" можно пройти обследование на ВИЧ (бесплатно, анонимно), на вирусные гепатиты В и С (бесплатно по мед. показаниям по направлению врача).
Исследование крови проводят в городской поликлинике (Московская 29) кабинет № 204 строго натощак с направлением от врача с 8.00 до 11.00 ежедневно ( кроме субботы и воскресенья)
ВИЧ (вирус иммунодефицита человека) является серьезным заболеванием, поражающим иммунную систему человека, приводящую к смертельно опасным состояниям. К сожалению, ежегодно регистрируются новые случаи заболеваемости, к ноябрю 2015 года в России выявлено 500 больных на 100000 населения. Вирус относится к семейству лентивирусов, виду ретровирус. В качестве среды существования вирус использует Т-лимфоциты, клетки иммунной системы, постепенно снижая защитный уровень организма. Как правило, от момента заражения ВИЧ до стадии иммунодефицита проходит несколько лет. ВИЧ-инфекция приводит к развитию синдрома приобретенного иммунодефицита (СПИД), который характеризуется частыми заболеваниями: грибковым поражением слизистых, рецидивирующими ОРВИ, атипичным течением пневмонии, злокачественными новообразованиями (саркома Капоши) и т.д.
Что такое профилактика ВИЧ?
Профилактика заражения ВИЧ-инфекцией заключается в комплексе мер, направленных на предотвращение заражения вирусом и лечения выявленных больных, а также санитарно-просветительной работе с населением, тематические уроки для школьников старших классов с разъяснением темы полового воспитания. В настоящее время разработана экстренная профилактика, которая проводится сразу после незащищенного полового контакта с помощью врача-дерматовенеролога. Существуют препараты, применение которых в кратчайшие сроки после вероятного заражения дает высокий процент защиты от развития инфекционного процесса.
Каковы пути передачи ВИЧ-инфекции?
ВИЧ передается от человека к человеку следующими путями:
- половой, в особенности, генитально-анальный, так как при этом половом акте отмечается травматизм слизистой оболочки, который способствует заражению. Аналогично, заражение происходит в 100% случаев при наличии эрозии шейки матки, а также сопутствующих ЗППП.
- вертикальный: от зараженной беременной женщины будущему ребенку.
- через нестерильные инструменты (операционный инструментарий, стоматологические инструменты, оборудование для маникюра и т.д.).
- при переливаниях крови, а также контакте с кровью: иглы, используемые наркозависимыми.
В группе риска заражения ВИЧ находится медицинский персонал, который работает с инструментарием и препаратами крови (хирурги, врачи скорой помощи, медицинские сестры), работники коммерческого секса, наркоманы. После проникновения вируса в организм начинается период "окна", или скрытый период: антитела к вирусу появляются в крови только через 1-3 месяца. Обследование должно быть проведено и на другие инфекции, передаваемые половым путем.
Как проводится профилактика заражения самостоятельно?
После полового контакта с предполагаемо инфицированным человеком следует принять меры безопасности: обмыть наружные половые органы мыльным раствором, ввести антисептические растворы в уретру (мужчинам) и влагалище (женщинам), мирамистин, гибитан, раствор хлоргексидина.
После травмы инструментарием или иглой рекомендуется постараться ликвидировать из раны содержимое, массируя кожу. После этого нужно обработать спиртовым раствором или антисептическим средством. После предполагаемого заражения ВИЧ любым путем, следует обратиться к врачу в кратчайшие сроки. Наиболее эффективной будет медикаментозная профилактика, проведенная не позднее 72 часов (в идеале спустя 2 часа или хотя бы сутки) после заражения.
Эффективна ли медикаментозная профилактика ВИЧ?
Экспериментальным путем было доказано, что при проникновении на слизистые оболочки вирус иммунодефицита поражает сперва клетки местной иммунной системы, которые затем (через двое суток) перемещаются в регионарные лимфоузлы; в крови вирус может определиться лишь через несколько суток.
Как проводится медикаментозная профилактика ВИЧ?
- Антиретровирусная терапия: применение препаратов с действием против ретровирусов. К ним относятся: ралтегравир, тенофовир, эмтрицитабин и другие. Существуют весьма эффективные комбинированные антиретровирусные препараты, например, Трувада (комбинация тенофовира и эмтрицитабина), Комбивир (зидовудин и ламивудин), также врач индивидуально подбирает комбинации противовирусных препаратов. Среди назначаемых препаратов находят применение энфувертид (противовирусный препарат, препятствующий проникновению вируса в клетку), эфавиренз (ингибитор фермента обратной транскриптазы), саквинавир (ингибитор фермента протеазы, препятствующий образованию активных белков вируса) и другие.
- Иммуномодуляторы: Ронколейкин, Ликопид и другие, призванные повысить защитную функцию организма.
- Препараты для защиты клеток печени от повреждающего воздействия лекарств: Метионир, Карсил, Берлитион 600 и т.д.
Медикаментозная профилактика продолжается в среднем 4 недели, после чего следует сдать анализ крови на антитела к ВИЧ, спустя 3, 6, 12 недель, 6 и 12 месяцев.
Возможны ли побочные эффекты медикаментозной профилактики?
Антиретровирусные препараты в ряде случаях оказывают побочные эффекты, которые проявляются в виде нарушения пищеварения, также в анализах крови можно обнаружить увеличение активности трансаминаз (аспартатаминотрансфераза, аланинаминотрансфераза) и снижение количества нейтрофилов. В ряде случаев после антиретровирусной терапии развивается инсулинорезистентность, нарушение липидного обмена. Побочные эффекты сведены к минимуму при правильном подходе к терапии, своевременном контроле и коррекции возможных изменений.
Лекарственная профилактика ВИЧ способна предотвратить развитие опасного заболевания, поэтому при малейшей вероятности заражения не стоит откладывать визит к врачу.
Врачи нашей клиники имеют многолетний опыт лечения заболеваний мужской и женской половой сферы. При появлении любых проявлений ЗППП, а также после незащищенного полового контакта или иного риска заражения, необходимо немедленно обратиться к врачу дерматовенерологу.
Гепатит это группа болезней, которые носят одно название и оказывают разрушительное действие, в основном, на печень.
Вирусы, вызывающие разные виды гепатита, по-разному попадают в организм. Поэтому и группа риска у каждого вида гепатита своя. Кто и каким гепатитом может заболеть и почему? Ответы на эти вопросы мы дадим в этой статье.
- употребление инъекционных наркотиков;
- половой контакт с человеком, у которого острая стадия болезни;
- плохая санитарная обстановка;
- проживание с человеком с вирусом гепатита А;
- отсутствие чистой воды;
- поездки в районы с высоким уровнем заболеваемости.
Не менее распространен вирус гепатита В. Однако, это гораздо более серьезная болезнь. По данным ВОЗ 240 миллионов человек во всем мире болеют хроническим гепатитом B. К сожалению, болезнь, перешедшая в хроническую стадию, неизлечима. Но сейчас ведется большая работа по детальному изучению этого вируса и разработке лекарства против этого заболевания. Поэтому, в скором времени эту болезнь смогут вылечить.
Опасность данной болезни в том, что при вирусе B, у человека повышается риск развития цирроза и злокачественной опухоли печени, что, зачастую, приводит к смерти. Возможность передачи гепатита B очень ограничены только через жидкости, выделяемые человеком. Наиболее часто хроническая стадия болезни развивается у детей, которые были инфицированы вирусом в возрасте до 6 лет. Но от вируса гепатита B существует вакцина, которая уменьшает риск заражения вирусом на 95%.
Основные группы риска заражения гепатитом B:
- лица, ведущие беспорядочную половую жизнь;
- лица, проживающие с инфицированным человеком;
- лица, имеющие половые контакты с инфицированным партнером;
- лица, употребляющие инъекционные наркотики;
- дети, родившиеся у инфицированных матерей;
- гомосексуалисты;
- больные, получающие частые переливания крови.
- лица, употребляющие инъекционные наркотики;
- лица, получающие переливание крови;
- дети, родившиеся у матерей с вирусом гепатита С;
- лица, имеющие половые контакты с инфицированным партнером;
- ВИЧ-положительные лица;
- лица, использующие интраназальные препараты;
- лица, нарушающие целостность покровов кожи.
Остальные виды гепатита менее распространены и передаются такими же путями, поэтому и группы риска схожи.
Даже если вы входите в группу риска, это не значит, что вы обязательно должны заболеть. Стоит помнить о профилактике, исключить из жизни дополнительные факторы риска и периодически проверяться на наличие вируса гепатит в больнице.
Остановимся подробнее на мерах профилактики каждой разновидности вирусных гепатитов:
Профилактика гепатита А:
- избегать употребления воды из незнакомых источников, не купаться в водоемах сомнительной чистоты (переполненные пляжи в период летнего зноя, водоемы, в которые стекают канализационные воды);
- соблюдение элементарных гигиенических норм, в частности мытье рук после каждого посещения туалета, по возвращению с улицы или перед едой;
- поддержание чистоты в помещениях;
- использование индивидуальных предметов личной гигиены;
- тщательное мытье овощей и фруктов перед употреблением, использование чистой проточной воды;
- в садоводстве и огородничестве нужно избегать использования некомпостированного помета в качестве удобрения.
Профилактика гепатита В:
- исключение случайных половых связей или как минимум использование презервативов при сексе с малознакомым партнером;
- исключение наркозависимости, в частности использования инъекционных наркотиков; в противном случае как минимум нужно следить за тем, чтобы одноразовые шприцы и иглы утилизировались сразу же после использования одним человеком;
- использование одноразовых инструментов при клиническом анализе крови;
- строгий контроль со стороны медицинских работников за использованием и дезинфекцией медицинских приборов и инструментария;
- исключение общего пользования предметами личной гигиены (станки для бритья, ножницы, наборы для маникюра);
- разработаны вакцины, применение которых рекомендовано лицам из группы повышенного риска, а также населению по желанию.
К группе риска заражения самым коварным и опасным из гепатитов относятся медики, работающие с кровью, пациенты, подвергающиеся хирургическому вмешательству, дети, родившиеся от зараженной матери, люди, ведущие беспорядочную половую жизнь и наркоманы. Важно понимать, что переливание крови как фактор риска заражения гепатитами опасно для того, кому переливают кровь, а не для самого донора.
Профилактика гепатита С:
- крайняя осторожность и избирательность при выборе стоматологической клиники, татуили маникюрного салона; по возможности, для маникюра например, приносить в салон собственные принадлежности;
- исключение общего пользования предметами личной гигиены (иногда это касается даже членов семьи);
- разборчивость в половых связях или наличие под рукой презерватива, который в необходимый момент может использоваться по назначению.
К сожалению, как раз против гепатита С вакцины не разработано.
Профилактика гепатита D:
- снова-таки контроль качества донорской крови;
- эффективные меры обеззараживания медицинских инструментов;
- тщательная дезинфекция оборудования в салонах красоты и тату-салонах;
- использование барьерной контрацепции при половых актах;
- вакцинация препаратом, предназначенным для профилактики гепатита В.
Профилактика гепатита E:
- ареал распространения вируса страны Средней Азии, а потому пребывая там нужно уделять внимание качеству и чистоте питьевой воды и продуктов питания:
- пить исключительно бутилированную или кипяченную воду;
- сырые овощи и фрукты употреблять только после того, как они хорошо вымыты чистой водой;
- избегать стрит-фуда.
Профилактика гепатита G:
- со стороны медицинского персонала ответственный подход к дезинфекции медицинских инструментов многоразового использования и проверке донорской крови;
- выполнение несложных медицинских манипуляций одноразовыми инструментами;
- применение барьерной контрацепции при половых контактах;
- от гепатита G разработана вакцина, о которой можно осведомиться в любом медицинском учреждении.
Внимание. При положительных и сомнительных реакциях, срок выдачи результата может быть увеличен до 10-ти рабочих дней. ВИЧ (вирус иммунодефицита человека), вызывающий СПИД (синдром приобретенного иммунодефицита) - принадлежит к семейству ретровирусов. Передается от человека к человеку при использовании загрязненных игл и шприцев для внутривенного введения наркотиков или терапевтических процедур, при сексуальных контактах, как гетеро, так и гомосексуальных. Передача вируса может произойти при переливании инфицированной крови и ее продуктов, донорстве органов или семенной жидкости, у медицинских работников - при ранении инфицированными иглами или инструментами. Заражение ВИЧ возможно путем его передачи от инфицированной матери ребенку (вертикальный путь), хотя современные методы профилактики с применением антиретровирусной терапии, при выполнении всех рекомендаций, позволяют снизить такой риск до минимума.
Процесс взаимодействия вируса с клеткой включает ряд стадий: связывание вируса с клеткой, освобождение его от оболочки, проникновение в цитоплазму, синтез ДНК по вирусной РНК, встраивание вирусной ДНК в геном клетки-хозяина. После этого начинается латентная стадия инфекции. В таком состоянии провирусная ДНК может существовать некоторое время, не проявляя активности и не влияя на жизнедеятельность клетки-хозяина. Пока нет экспрессии вирусных белков, нет и иммунного ответа на вирус. Антитела к ВИЧ, характеризующие иммунный ответ организма, появляются после активации вирусной ДНК и начала активного размножения вируса. Длительность латентного периода зависит от ряда факторов, включая и индивидуальные генетические особенности организма.
В первые недели инфекции, еще до появления антител к вирусу (т.е. до сероконверсии), в образцах сыворотки или плазмы можно выявить присутствие антигенов ВИЧ, в том числе его капсидного белка р24. Позже, после сероконверсии, он обычно становится недетектируемым.
Комбинированные тест-системы 4-го поколения, к которым относится тест HIV Ag/Ab Combo (Architect, Abbott), выявляют как антитела к ВИЧ 1 и 2 типов, так и антиген р24 ВИЧ, что позволяет проводить раннее обнаружение инфекции. К особым характеристикам применяемого в лаборатории ИНВИТРО скринингового теста для выявления ВИЧ-инфекции стоит отнести высокую специфичность исследования (> 99,5%); 100% чувствительность анализа к антителам, характерным для периода сероконверсии, и чувствительность теста к антигену р24 порядка 18 пг/мл.
Порядок проведения лабораторного обследования на ВИЧ строго регламентирован приказами МЗ РФ и включает в себя этап скринингового (отборочного) исследования наличия антител к ВИЧ иммуноферментными (ИФА) методами, разрешенными к использованию, и этап верификационного (подтверждающего) более развернутого исследования в лаборатории городского центра СПИД. Следует отметить, что даже лучшие скрининговые ИФА-системы не гарантируют 100% специфичности, то есть существует некоторая вероятность получения неспецифических, ложноположительных результатов, связанных с особенностями сыворотки крови пациента. Поэтому положительный результат скринингового ИФА обследования может не подтвердиться в подтверждающих тестах, после чего пациенту выдадут отрицательный или неопределенный результат. При неопределенном результате подтверждающего исследования тестирование следует повторить в динамике через 2-3 недели.
- Увеличение лимфатических узлов более двух областей.
- Лейкопения с лимфопенией.
- Ночная потливость.
- Резкое похудание неясной причины.
- Диарея более трех недель неясной причины.
- Лихорадка неясной причины.
- Планирование беременности.
- Предоперационная подготовка, госпитализация.
- Выявление следующих инфекций или их сочетаний: туберкулез, манифестный токсоплазмоз, часто рецидивирующая герпесвирусная инфекция, кандидоз внутренних органов, повторные невралгии герпес-zoster, вызванная микоплазмами, пневмоцистой или легионеллами пневмония.
- Саркома Капоши в молодом возрасте.
- Случайные половые контакты.
Интерпретация результатов исследований содержит информацию для лечащего врача и не является диагнозом. Информацию из этого раздела нельзя использовать для самодиагностики и самолечения. Точный диагноз ставит врач, используя как результаты данного обследования, так и нужную информацию из других источников: анамнеза, результатов других обследований и т.д.
Единицы измерения в Независимой лаборатории ИНВИТРО: тест качественный.
В случае обнаружения антител к ВИЧ или антигена в скрининговом иммуноферментном тесте пробу сыворотки отправляют для исследования подтверждающим методом иммуноблота в городской центр СПИД, который верифицирует положительные и неопределенные результаты.
Информация об организации подтверждена: 23.08.2017
Иммунология




Цена за исследование фактора некроза опухоли

Цена за иммунный статус

Общие, биохимические анализы мочи, кала
Бактериологические исследования
Цена за анализ на лактобактерии, определение ДНК в соскобе эпителиальных клеток урогенитального тракта
Цена за выявление возбудителей ИППП
Инфекционная диагностика, ПЦР диагностика, серологическая диагностика

Цена за цитологическое исследование

Цена за анализ крови






Цена за анализ на ВПЧ

Цена за антигенный тест

Цена за антитела и антигены

ДНК, генетические анализы
Цена за 3-х человек, дедушка и бабушка с отцовской стороны, ребенок
Цена за 2-х человек, предполагаемый отец, ребенок
Цена за 3-х человек, дедушка и бабушка с материнской стороны, ребенок
Цена за 2-х человек, предполагаемая мать, ребенок
Онкомаркеры
Цена за ПСА общий
Цена за исследование рака яичников
Цена за исследование опухолевых заболеваний крови
Цена за исследование злокачественной меланомы
Цена за исследование плоскоклеточного рака
Цена за исследование на рак легких
Цена за исследование на рак яичников
Цена за исследование на рак молочной железы
Цена за исследование на рак поджелудочной железы
Аллергология

Цена за анализ на панель аллергенов на бытовую пыль, плесневые и дрожжевые грибки

Цена за тест на панель аллергенов на шерсть, пух, перо, перхоть, экскременты, слюну домашних животных

Цена за панель аллергенов на лекарственные препараты, противоаллергические средства, анестетики
Номенклатура МЗРФ (Приказ №804н): A26.06.049.001 "Исследование уровня антител классов M, G (IgM, IgG) к вирусу иммунодефицита человека ВИЧ-1/2 и антигена p24 (Human immunodeficiency virus HIV 1/2 + Agp24) в крови"
Биоматериал: Сыворотка крови
Срок выполнения (в лаборатории): 1 р.д. *
Описание
ВИЧ-инфекция - заболевание, вызываемое вирусом иммунодефицита человека (ВИЧ), длительное время персистирующего в лимфоцитах, макрофагах, клетках нервной ткани, в результате чего развивается медленно прогрессирующее поражение иммунной и нервной систем организма, проявляющееся вторичными инфекциями, опухолями, подострым энцефалитом и другими патологическими изменениями.
Определение антител к вирусу иммунодефицита человека является основным методом лабораторной диагностики ВИЧ-инфекции. В основе метода лежит иммуноферментный анализ (чувствительность более 99,5%, специфичность более 99,8%). Антитела к ВИЧ появляются у 90-95% инфицированных в течение 3 месяцев после заражения, у 5-9 % - через 6 месяцев и 0,5-1% - в более поздние сроки. В стадии СПИДа количество антител может снижаться вплоть до полного исчезновения.
Результаты исследования на ВИЧ независимо от их результата выдаются только при личном обращении пациента в лабораторное отделение. При обследовании несовершеннолетних (до 14 лет) детей — законному представителю, указанному в заказе.
Результаты выдаются при предъявлении договора, сметы и документа, удостоверяющего личность самого пациента или представителя пациента, указанного в заказе.
По телефону и электронной почте результаты исследования не сообщаются.
Показания к назначению
- Ранняя диагностика ВИЧ-инфекции, мониторинг течения заболевания;
- Обнаружение ВИЧ-инфекции у доноров крови, а также детей;
- Определение прогноза течения СПИД и контроль за проводимой терапией у пациентов со СПИД;
- Лейкопения с лимфопенией;
- Нарушение стула (диарея) на протяжении более чем 3-х недель;
- Ночная потливость
- Резкое снижение веса без причины;
- Увеличение более чем 2-х лимфоузлов в разных областях;
- Подготовка к операции;
- Планирование беременности%
- Выявленные инфекции (токсоплазмоз, туберкулез, рецидивирующая герпесвирусная инфекция;
- Саркома Капоши в молодом возрасте;
- Незащищенные половые контакты.
Подготовка к исследованию
Специальной подготовки к исследованию не требуется. Взятие крови проводится натощак или не ранее, чем через 4 часа после необильного приема пищи. Допустимо пить чистую не минеральную и не газированную воду. Чай, кофе, сок запрещаются.
Внимание! При сдаче исследования АТ и АГ к ВИЧ ½ для медицинского освидетельствования в соответствии с законодательством РФ обязательно предоставление документов и следующих данных:
1) Для жителей Москвы и Московской области:
- Фамилия, имя, отчество
- День, месяц и год рождения
- Сведения о регистрации
- Паспорт
2) Для жителей других регионов РФ и иностранных граждан дополнительно - ксерокопию (скан) паспорта
- Фамилия, имя, отчество
- День, месяц и год рождения
- Сведения о регистрации
- Паспорт
- Ксерокопия (скан) паспорта.
При отсутствии паспорта пациент вправе оформить анонимную заявку для сдачи биоматериала.
При анонимном обследовании заявке и полученному от клиента образцу биоматериала присваивается номер, известный только пациенту и медперсоналу, оформлявшему заказ.
Результаты исследований, выполненных анонимно, не могут быть представлены для госпитализации, профессиональных осмотров и не подлежат регистрации в ОРУИБ.
Получить результаты анализов при анонимной сдаче возможно только лично при предъявлении чека.
Интерпретация результатов/Информация для специалистов
- Отрицательный результат исследования указывает на отсутствие антител к ВИЧ ½ и антигена р24 в сыворотке крови.
- Отрицательный результат лаборатория выдает сразу по его готовности.
- При получении положительного результата — выявлении антител к ВИЧ½ и/или антигена р24 — во избежание ложноположительных результатов в лаборатории анализ повторяют еще два раза.
- Вне зависимости от полученных результатов исследования проба крови пациента и результаты 3-х исследований направляются лабораторией в региональный центр СПИД для подтверждения положительного результата или верификации неопределенного результата. В таких случаях окончательный ответ по данному исследованию выдает региональный центр СПИД. Срок выдачи результата увеличивается до 10 дней.
Где сдать анализ?
Адреса медицинских центров, в которых можно заказать исследование, уточняйте по телефону 8-800-100-363-0
Все медицинские центры СИТИЛАБ в г. Вологда >>
Биоматериал: Сыворотка крови
Срок: от 1 р.д. *
Основные социально значимые инфекции (ВИЧ, сифилис, гепатиты В и С)
Биоматериал: Сыворотка крови
Срок: от 1 р.д. *
Основные социально значимые инфекции (ВИЧ, сифилис, гепатиты В и С)
Биоматериал: Сыворотка крови
Срок: от 1 р.д. *
Основные социально значимые инфекции (ВИЧ, сифилис, гепатиты В и С)
Биоматериал: Сыворотка крови, плазма с фторидом натрия, кровь с ЭДТА, плазма-цитрат, моча
Срок: от 1 р.д. *
Расширенный комплекс исследований, необходимых для диспансеризации (оценка работоспособности всех органов), госпитализации в стационар.
* На сайте указан максимально возможный срок выполнения исследования. Он отражает время выполнения исследования в лаборатории и не включает время на доставку биоматериала до лаборатории.
Приведенная информация носит справочный характер и не является публичной офертой. Для получения актуальной информации обратитесь в медицинский центр Исполнителя или call-центр.
1. Пройдите тест на ВИЧ, если:
- Если у Вас были половые контакты без презерватива. Даже единственный вагинальный, анальный или оральный контакт без презерватива может привести к заражению.;
- Если Вы пользовались шприцами или иглами, которыми кто-то уже пользовался до Вас. ВИЧ может также передаваться черед общую ёмкость для забора наркотика, даже если используются индивидуальные шприцы.;
- Если Вам делали переливание крови до 1989 года;
- Если при несчастном случае Вы соприкасались с кровью другого человека;
- Если Вы ждете ребенка;
- Если у Вас есть передающиеся половым путем инфекции, гепатит В или С или туберкулез;
2. Пройдите тест, если у Вас проявились:
- Беспричинная большая потеря веса
- Постоянное чувство усталости и бессилия
- Продолжающаяся несколько недель повышенная температура
- Потение по ночам
- Сухой кашель, не вызванный курением, бронхитом или воспалением легких
- Увеличенные лимфатические узлы на шее, в подмышках и/или паху
Кому назначает врач тестирование на ВИЧ?
Врач предлагает пройти тестирование на ВИЧ следующим лицам в следующих ситуациях:
- Доноры крови и ее продуктов (тест обязательный);
- Доноры клеток, тканей и органов (тест обязательный);
- Все беременные при постановке на учет и на 30-32-ой неделе беременности;
- Все люди, обращающиеся на прием к врачу (дерматовенерологу, гинекологу, урологу, семейному врачу) в случае подозрения на заражение инфекциями, передающихся половым путем (в соответствии с правилами лечения инфекций, передающихся половым путем);
- Все люди, обращающиеся на прием к врачу-пульмонологу с подозрением на туберкулез (согласно инструкциям по диагностике, лечению и наблюдению за лечением туберкулеза);
- Все пациенты с индикаторными заболеваниями;
Когда детям нужно проходить обследование на ВИЧ?
Дети ВИЧ-позитивных женщин обследуются на ВИЧ по методу PCR в целом 4 раза: в течение первых двух недель жизни, в возрасте 1 месяца, в 3 месяца и в 6 месяцев. В дальнейшем ребенок обследуется на антитела к ВИЧ в год и в полтора года. Это делается для того, чтобы выяснить заражен ребенок или нет. Окончательно сказать, что ребенок не заражен можно после того, как ему исполнится полтора года.
Зачастую ВИЧ-инфекция развивается без всяких симптомов, либо они схожи с признаками простуды или переутомления. Поэтому, даже если вы ощущаете себя абсолютно здоровым, пройдите тестирование после эпизодов, которые могли быть связаны с риском заражения.
Заболевания, в связи с которыми показано тестирование на ВИЧ:
- туберкулез (как легких, так и других органов);
- заболевания, передающиеся половым путем (в том числе уреаплазмоз, микоплазмоз, генитальный герпес, папиломовирусная инфекция, гонорея, сифилис, хламидиоз, трихомониаз);
- лимфома;
- саркома Капоши;
- рак шейки матки и анального отдела и преканцерозные состояния;
- опоясывающий лишай у лиц моложе 65 лет;
- простой герпес;
- острый или хронический гепатит B и гепатит C;
- синдром мононуклеоза;
- лейкопения неясного происхождения или тромбоцитопения продолжительностью > 4 недель;
- генерализованный себорейный дерматит/фолликулит;
- генерализованные грибковые инфекции (в том числе оппортунистические грибковые инфекции);
- генерализованные бородавки и инфекционные моллюски;
пневмония, повторяющаяся в течение одного года (более одного раза в год).;
В случае выявления хронического заболевания пациента сразу следует протестировать и диагностировать в дальнейшем один раз в год.
Когда сдавать тест на ВИЧ?
Если у Вас произошла рискованная ситуация, то сдавать кровь на ВИЧ нужно не менее чем через 2-3 недели после риска.
1) В поликлинике по месту жительства. Для этого нужно получить направление на анализ у терапевта или инфекциониста.
2) В Центре СПИДа, ул. Шуменская, д. 16. С понедельника по четверг – с 8:30 до 11:30, с 12:45 до 14:30 (с 14:30 до 15:00 – кварцевание), пятница – с 8:00 до 12:30
Анализ на ВИЧ (методом ИФА) будет готов через 5 рабочих дней.
Призывникам. Во избежание подделки результатов справка выдается только на основании анализов, сделанных в Областном Центре СПИДа. При выдаче справки об отсутствии ВИЧ-инфекции областной Центр СПИДа несет юридическую ответственность.
Беременным женщинам и их партнерам: в женской консультации или поликлинике по месту жительства (партнер должен предоставить справку в ЖК)
1) В кабинетах низкопорогового доступа к тестированию.
2) На массовых акциях Центра СПИД экспресс-тестированием. Анонимно (без документов), результат теста сообщается через 10-15 минут, выдача справки не осуществляется.
3) В платных лабораториях предоставляется услуга анонимной сдачи анализа на ВИЧ
Расписание экспресс-тестирования на ВИЧ в марте 2020 г.
Обследование на ВИЧ-инфекцию осуществляется бесплатно для граждан Российской Федерации при предъявлении паспорта гражданина Российской Федерации.
Бесплатные медицинские услуги оказываются населению Челябинской области при наличии паспорта гражданина Российской Федерации, временной регистрации, либо регистрации по месту жительства на территории Челябинской области.
В связи с тем, что Центром СПИДа оказывается специализированная помощь, результат анализа вклеивается в карту, которая заводится при обращении. Если вам необходимо получить результат анализа на руки (мужья беременных женщин, готовящиеся к операции и др.), то вам следует обратиться в поликлинику по месту жительства, предварительно взяв направление на анализ у терапевта или врача-инфекциониста.
В остальных случаях возможно оказание платных медицинских услуг в соответствии с утвержденном прейскурантом.
Для сдачи анализа на ВИЧ необходимо обратиться с паспортом в регистратуру для оформления первичной медицинской документации.
Расписание приема:
Выдача справок об отсутствии ВИЧ-инфекции лицам до 18 лет:
с понедельника по пятницу – с 13:00 до 15:00
Дотестовое консультирование: с понедельника по пятницу – с 8:00 до 12:00, с 12:30 до 15:00
Выдача справок об отсутствии ВИЧ-инфекции лицам старше 18 лет:
Шуменская, 16, кабинет № 216 (до- и послетестовое консультирование)
с понедельника по пятницу – с 08:00 до 10:00, с 13.00 до 15.30
справка для лиц, собирающихся на службу в ВС РФ и на учебу в военные заведения – бесплатная
справка для лиц, собирающихся служить по контракту, на работу, связанную со службой в силовых структурах и военных ведомствах – платная (200 руб.)
Дотестовое консультирование: с понедельника по пятницу – с 8:00 до 12:30, с 13:00 до 15:30
с понедельника по четверг – с 8:00 до 15:00
пятница – с 8:00 до 14:00
Анализ на ВИЧ (методом ИФА) будет готов через 5 рабочих дней.
Уточнить информацию можно по телефону: 8-800-3-0000-34
Остальные результаты можно получить через 7-10 дней на приеме у врача-инфекциониста (заранее позаботьтесь о талоне ( Госуслуги / Портал записи ))
Телефон регистратуры: 214-99-08
Для получения платных медицинских услуг в соответствии с утвержденным прейскурантом цен необходимо с паспортом обратиться в регистратуру для оформления первичной медицинской документации. Конфиденциальность гарантируется!
Оказание платных медицинских услуг осуществляется в соответствии с графиком работы специалистов Центра СПИДа.
Читайте также:


